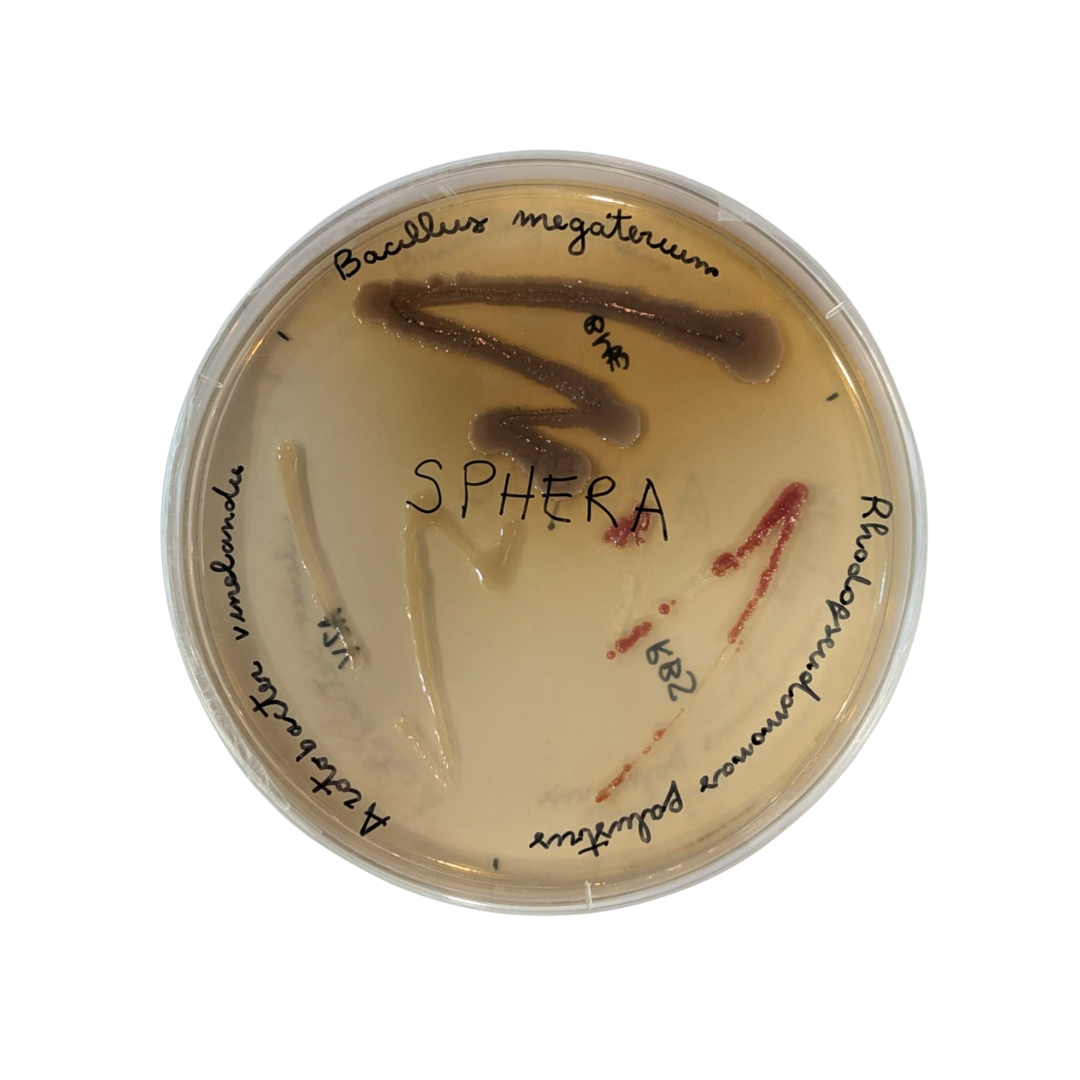

Opis
SPHERA to innowacyjny produkt łączący działanie grzybów mikoryzowych (Rhizoglomus irregulare, Glomus mosseae, Funneliformis caledonium) z pożytecznymi bakteriami (Azotobacter vinelandii, Bacillus megaterium, Rhodopseudomonas palustris), tworząc kompletny mikrobiom wspierający roślinę od najwcześniejszych etapów rozwoju. Dzięki temu połączeniu SPHERA poprawia kiełkowanie nasion i ukorzenianie siewek, optymalizuje pobieranie składników pokarmowych oraz podnosi odporność roślin na stres biotyczny i abiotyczny.
MECHANIZM DZIAŁANIA
Zawarte w SPHERA grzyby mikoryzowe szybko tworzą symbiotyczne połączenie z korzeniami roślin, znacząco zwiększając zdolność roślin do pobierania kluczowych składników odżywczych, takich jak fosfor, potas i mikroelementy. Wzmacnia to system korzeniowy, poprawia umocowanie w glebie oraz zwiększa tolerancję roślin na stres wodny i środowiskowy.
Jednocześnie pożyteczne bakterie działają synergicznie: wiążą azot atmosferyczny, dostarczają łatwo przyswajalny azot i stymulują rozwój korzeni, rozpuszczają fosfor związany w glebie oraz produkują metabolity wtórne, witaminy, antyoksydanty i fitohormony poprawiające ogólną kondycję roślin.
SPECYFICZNE DZIAŁANIE — INOKULUM GRZYBÓW MIKORYZOWYCH
Numer rejestracyjny nawozu organicznego w Republice Włoskiej: 0025486/19
SKŁAD
Typ preparat poprawiający jakość gleby
Zawartość mikoryz: 5%
Zawartość bakterii ryzosferowych: 10¹⁰ jtk/g
Brak GMO i patogenów.
Właściwości fizykochemiczne
|
Parametr |
Wartość |
|
pH |
7 ± 0.5 |
|
Gęstość |
1.20 ± 0.5 |
|
Kolor |
Jasnobrązowy |
|
Zapach |
Znikomy |
|
Rozpuszczalność |
W wodzie |
FORMULACJA
Płynna
KLASYFIKACJA
Brak
OPAKOWANIE
- Butelka 1 L
- Kanister 5 L
INSTRUKCJA STOSOWANIA
|
Uprawa |
Dawka |
|
Uprawy polowe i pod osłonami |
1–2 L/ha |
|
Szkółki (rośliny w pojemnikach) |
300–500 ml/1000 m² |
|
Warzywa liściowe, sałaty, rukola, … |
100–300 ml/1000 m² |
|
Truskawki, maliny borówki, … |
100–300 ml/1000 m² |
|
Świeże i aromatyczne zioła |
100–300 ml/1000 m² |
|
Kwiaty i rośliny ozdobne |
100–300 ml/1000 m² |
|
Sadownictwo (jabłonie, grusze, morele, brzoskwinie, wiśnie, kiwi) |
1–2 L/ha |
|
Winorośl |
1–2 L/ha |
|
Trawniki |
1–2 L/ha |
|
Uprawy wielkoobszarowe |
1–2 L/ha |
ZALECENIA
- Przed użyciem dobrze wstrząsnąć.
- Stosować równomiernie, mieszać w trakcie aplikacji.
- Aby pobudzić rozwój mikroorganizmów, zaleca się mieszać produkt w proporcji 1:1 z CARBOGEN L.
- Zaleca się wykonanie prób na niewielkiej liczbie roślin przed zastosowaniem na całej powierzchni.
- W razie potrzeby zabieg powtórzyć.
Po kilku latach intensywnych obserwacji na różnych rodzajach upraw możemy stwierdzić, że SPHERA stosowana razem z TRIASH i CARBOGEN L daje wyjątkowe efekty w zakresie:
– wzrostu korzeni
– krzewienia i wzrostu masy zielonej
– szybkości kwitnienia
– szybkości i ilości owocowania
– smaku i zawartości substancji świadczących o jakości plonu.